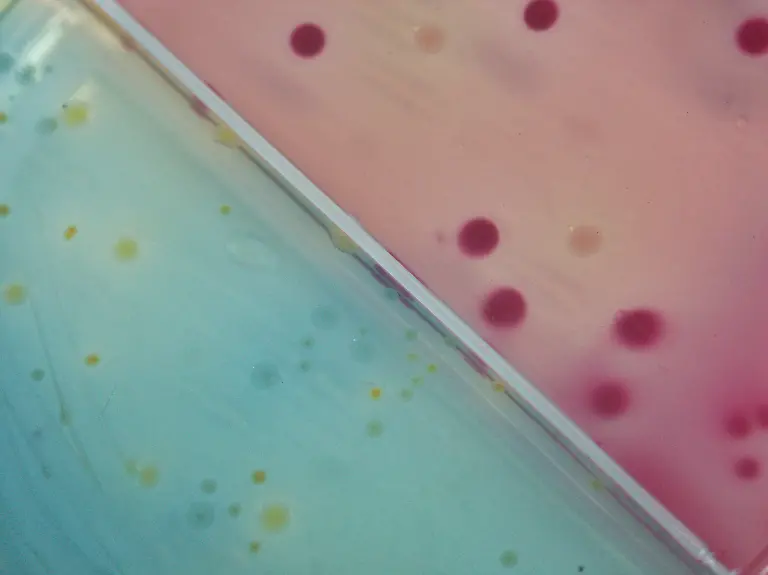
527842-original-R-K-B-by-Cornelia-Menichelli-pixelio-de

Bilderserien

Keine Desinfektion im HaushaltDer richtige Umgang mit Keimen
24.11.2012, 13:39 Uhr
Mit Darmkeimen infizierte Neugeborene, Noro-Viren im Schulessen und eine große Zahl an EHEC-Erkrankungen: Die Nachrichten um krankmachende Keime können Angst machen. Dabei leben wir in einer Welt, die noch nie so sauber war wie heute.